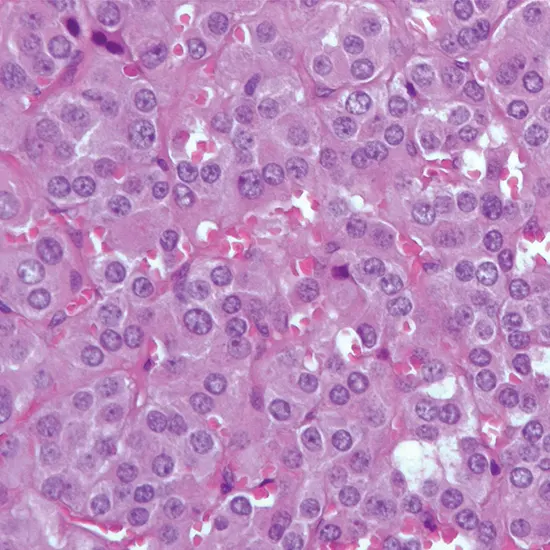
pheochromocytoma

Book Pheochromocytoma Appointment Online Near me at the best price in Delhi/NCR from Ganesh Diagnostic. NABL & NABH Accredited Diagnostic centre and Pathology lab in Delhi offering a wide range of Radiology & Pathology tests. Get Free Ambulance & Free Home Sample collection. 24X7 Hour Open. Call Now at 011-47-444-444 to Book your Pheochromocytoma at 50% Discount.
Pheochromocytoma is an uncommon tumor type that grows in the adrenal glands, which are small glands located on top of the kidneys. Pheochromocytomas are usually benign (non-cancerous), but they can be malignant (cancerous) in some cases. Pheochromocytomas arise from cells that produce adrenaline and noradrenaline, which are hormones that help regulate blood pressure and the body's response to stress.
The symptoms of pheochromocytoma includes palpitations, rapid heartbeat, headaches, sweating, flushing, anxiety and tremors. It can also cause abdominal pain, nausea, vomiting, and weight loss.
Diagnosis of pheochromocytoma typically involves blood and urine tests to measure levels of adrenaline, noradrenaline, and their breakdown products. Imaging studies such as computed tomography (CT) scan, magnetic resonance imaging (MRI), or metaiodobenzylguanidine (MIBG) scintigraphy may be used to locate the tumor.
| Plasma Free metanephrines | 3000 | |
| Blood Glucose (F, PP) | 80 | |
| Creatinine 24 Hour Urine | 125 | |
| 24 Hour Urine catecholamines | 1380 | |
| Metanephrines, 24 Hour Urine | 4565 | |
| MRI Abdomen scan with contrast | 8000 | |
| MR Spectroscopy | 4000 | |
| Total Price | 21150 |
Genetic testing may also be recommended in some cases, as pheochromocytomas can be associated with certain genetic syndromes such as multiple endocrine neoplasia (MEN) types 2A and 2B, von Hippel-Lindau syndrome, and neurofibromatosis type 1
| Test Type | Pheochromocytoma |
| Includes | Pheochromocytoma (Common Diseases) |
| Preparation | |
| Reporting | Within 24 hours* |
| Test Price |
₹ 21150
|

Early check ups are always better than delayed ones. Safety, precaution & care is depicted from the several health checkups. Here, we present simple & comprehensive health packages for any kind of testing to ensure the early prescribed treatment to safeguard your health.